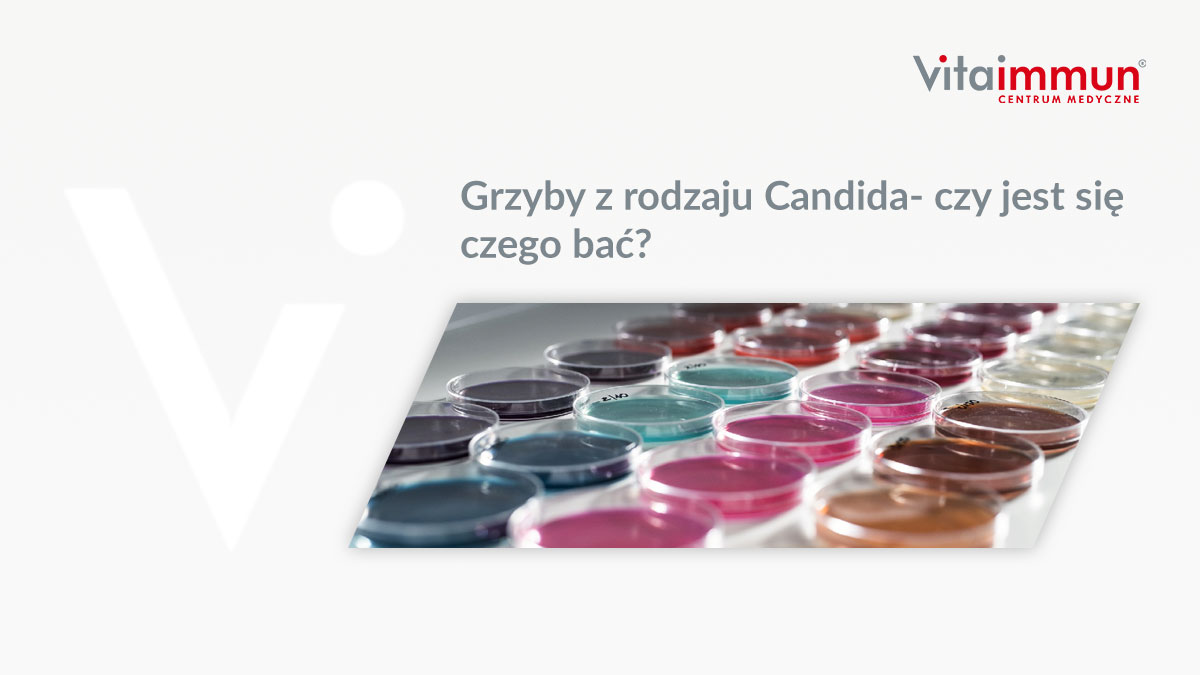
Grzyby z rodzaju Candida- czy jest się czego bać?

Vitaimmun
Grzyby z rodzaju Candida- czy jest się czego bać?
Znaczna część osób na samo wspomnienie słowa „Candida” zaczyna się bać. Drożdżaki, grzyby – to musi być coś złego. Ale czy na pewno tak jest? Na wstępnie należy zaznaczyć, iż grzyby drożdżopodobne z rodzaju Candida są szeroko rozpowszechnione w środowisku. Znanych jest około 200 gatunków tego rodzaju drożdżaka, z czego 15 gatunków scharakteryzowano jako chorobotwórcze dla człowieka. Dominującym wśród Candida spp. gatunkiem jest Candida albicans (44,8% diagnozowanych zakażeń), Candida glabrata (28,1%) oraz Candida parapsilosis (10,4%).
Spis treści
Wszechobecne Candida
Drożdżaki z rodzaju Candida albicans znajdują się m.in. w glebie, na zwierzętach, na powierzchni wielu przedmiotów użytku codziennego jak i w pokarmie. Stanowią także część składową fizjologicznej mikrobioty błon śluzowych przewodu pokarmowego, układu oddechowego oraz moczowo-płciowego i skóry.
W warunkach zachowanej homeostazy, u zdrowych osób, Candida albicans nie prowadzi do rozwoju chorób. Jest tzw. organizmem komensalnym, co oznacza, że czerpie z naszego organizmu określone korzyści jak np. dostęp do pożywienia, jednocześnie nie wyrządzając szkód.
W warunkach patologicznych może jednak dochodzić do przerostu drożdżaków w organizmie i rozwoju objawów chorobowych. Istnieją różne określenia na choroby wywołane przez grzyby z rodzaju Candida. Są to tzw. kandydozy, kandidiazy oraz drożdżyce. Każde z ich określeń dotyczy tego samego problemu.
Kandydozy są zazwyczaj zakażeniami endogennymi. Wynika to właśnie z faktu, iż drożdżaki z rodzaju Candida (w głównej mierze C. albicans) stanowią naturalną mikrobiotę przewodu pokarmowego, skóry oraz pochwy. Istnieje także możliwość transmisji z człowieka na człowieka oraz zakażenia szpitalnego.
Z klinicznego punktu widzenia, kandydozy dzieli się na powierzchniowe (np. kandydoza jamy ustnej), kandydozy układowe (jednoukładowe bądź wieloukładowe) oraz grzybice uogólnione (związane z obecnością grzybów we krwi).
Kandydoza powierzchniowa
Do kandydozy powierzchownej predysponuje m.in. stosowanie inhibitorów pompy protonowej, wziewnych glukokortykosteroidów, cukrzyca, antybiotykoterapia czy nieprawidłowe stosunki w składzie mikroflory przewodu pokarmowego, błon śluzowych i skóry. Warto zwrócić uwagę na fakt, iż u tych osób – mimo predyspozycji do rozwoju infekcji powierzchniowych – rzadko dochodzi do rozwoju kandydozy inwazyjnej. Powierzchowne kandydozy choć występują z dużą częstotliwością, nie są śmiertelne.
Grzybice uogólnione
Do kandydozy układowej/ uogólnionej predysponuje:
- głęboka neutropenia
- stosowanie leków immunosupresyjnych
- AIDS
- cewników wewnątrznaczyniowych
- implantację protez z tworzyw sztucznych
- przeszczepy narządowe
- zabiegi chirurgiczne w obrębie jamy brzusznej
- choroby nowotworowe
- ciężkie oparzenia
- ostre zapalenie trzustki
W tym artykule skupimy się natomiast głównie na zwiększonej kolonizacji grzybiczej przewodu pokarmowego, bez jawnej kandydozy.
Czy każdy ma grzyby w przewodzie pokarmowym?
Jak wspomniano wcześniej – grzyby z rodzaju Candida stanowią fizjologiczny element mikrobioty jelitowej. Za normę fizjologiczną liczebności tych grzybów w jelicie umownie uznaje się maksymalnie 10^3CFU (jednostek tworzących kolonię) na gram kału, w wyniku czego każda wartość powyżej wskazanej traktowana jest jako przerost grzybiczy.
Dysbioza może być efektem antybiotykoterapii, częstej farmakoterapii (np. stosowania niesteroidowych leków przeciwzapalnych), przewlekłego stresu (zarówno fizyczny jak i psychiczny), otyłości, stosowania inhibitorów pompy protonowej, przyjmowania doustnych preparatów z żelazem (które mogą powodować obniżenie bakterii z rodzaju Lactobacillus i Bifidobacterium). Czynniki te prowadzić mogą do zmniejszenia liczebności drobnoustrojów konkurujących z grzybami o miejsca receptorowe w jelicie. Sprzyja to przerostowi grzybiczemu i następczej kolonizację jelita grzybami, doprowadzając do ich przerostu ponad wspomnianą normę.
Widać więc, iż czynniki sprzyjające rozwojowi dysbiozy jelitowej predysponują także do zwiększonej kolonizacji grzybiczej przewodu pokarmowego. Z tego względu uznaje się, iż nadmierna kolonizacja przewodu pokarmowego drożdżakami z rodzaju Candida jest objawem problemu, nie zaś jego przyczyną.
Profilaktyka przeciwgrzybicza
Oznacza to, że w kontekście przerostu drożdżaków w przewodzie pokarmowym istotna jest przede wszystkim profilaktyka uwzględniająca możliwe ograniczenie czynników ryzyka prowadzących do rozwoju dysbiozy jelitowej, przy jednoczesnej maksymalizacji działań wpływających korzystnie na układ mikrobiomu.
Jeśli już wiemy, że stabilna i prawidłowa mikrobiota jelitowa jest jednym z głównych elementów chroniącym przed przerostem Candida w przewodzie pokarmowym (dla przypomnienia, jest to wartość powyżej 10^3 CFU na gram kału), zastanówmy się co możemy zmienić w naszej diecie, aby pozbyć się tego problemu.
O tym będziecie mogli przeczytać w drugiej części artykułu. Zapraszamy 🙂
Bibliografia:
- Adrian Man, Cristina Nicoleta Ciurea, et al. New perspectives on the nutritional factors influencing growth rate of Candida albicans in diabetics. An in vitro study. Mem Inst Oswaldo Cruz. 2017 Sep; 112(9): 587–592.
- Rogalski P. Kandydoza przewodu pokarmowego — fakty i mity. Gastroenterologia Kliniczna 2010, tom 2, nr 3, 87–97 Copyright © 2010 Via Medica.
- Yousuf S., Ahmad A., Khan A. et al. Effect of diallyldisulphide on an antioxidant enzyme system in Candida species, Can J Microbiol., 2010 Oct;56(10):816-21.
- Matsubara V.H., Bandara H. M. H. N., Mayer M.P.A. et al. Probiotics as Antifungals in Mucosal Candidiasis, Clinical Infectious Diseases, 2016;62(9):1143–53.
- Goel N., Rohilla H., Singh G. et al. Antifungal Activity of Cinnamon Oil and Olive Oil against Candida Spp. Isolated from Blood Stream Infections, J Clin Diagn Res, 2016; 10(8).
- Ciarlo E., Heinonen1 T., Herderschee1 J. et al. Impact of the microbial derived short chain fatty acid propionate on host susceptibility to bacterial and fungal infections in vivo, Sci Rep, 2016; 6: 37944.
- Carol A. Kumamoto. Inflammation and gastrointestinal Candida colonization. Curr Opin Microbiol. 2011 Aug; 14(4): 386–391.
- Staniszewska M, Bondaryk M, Piłat J. i wsp. Czynniki zjadliwości Candida Albicans. Przegl Epidemiol 2012; 66: 629 – 633.
- Kearney T. W. Gunsalus, Stephanie N. Tornberg-Belanger, et al. Manipulation of Host Diet to Reduce Gastrointestinal Colonization by the Opportunistic Pathogen Candida albicans. mSphere. 2016 Jan-Feb; 1(1): e00020-15.
Autorem wpisu jest mgr Łukasz Sieńczewski
